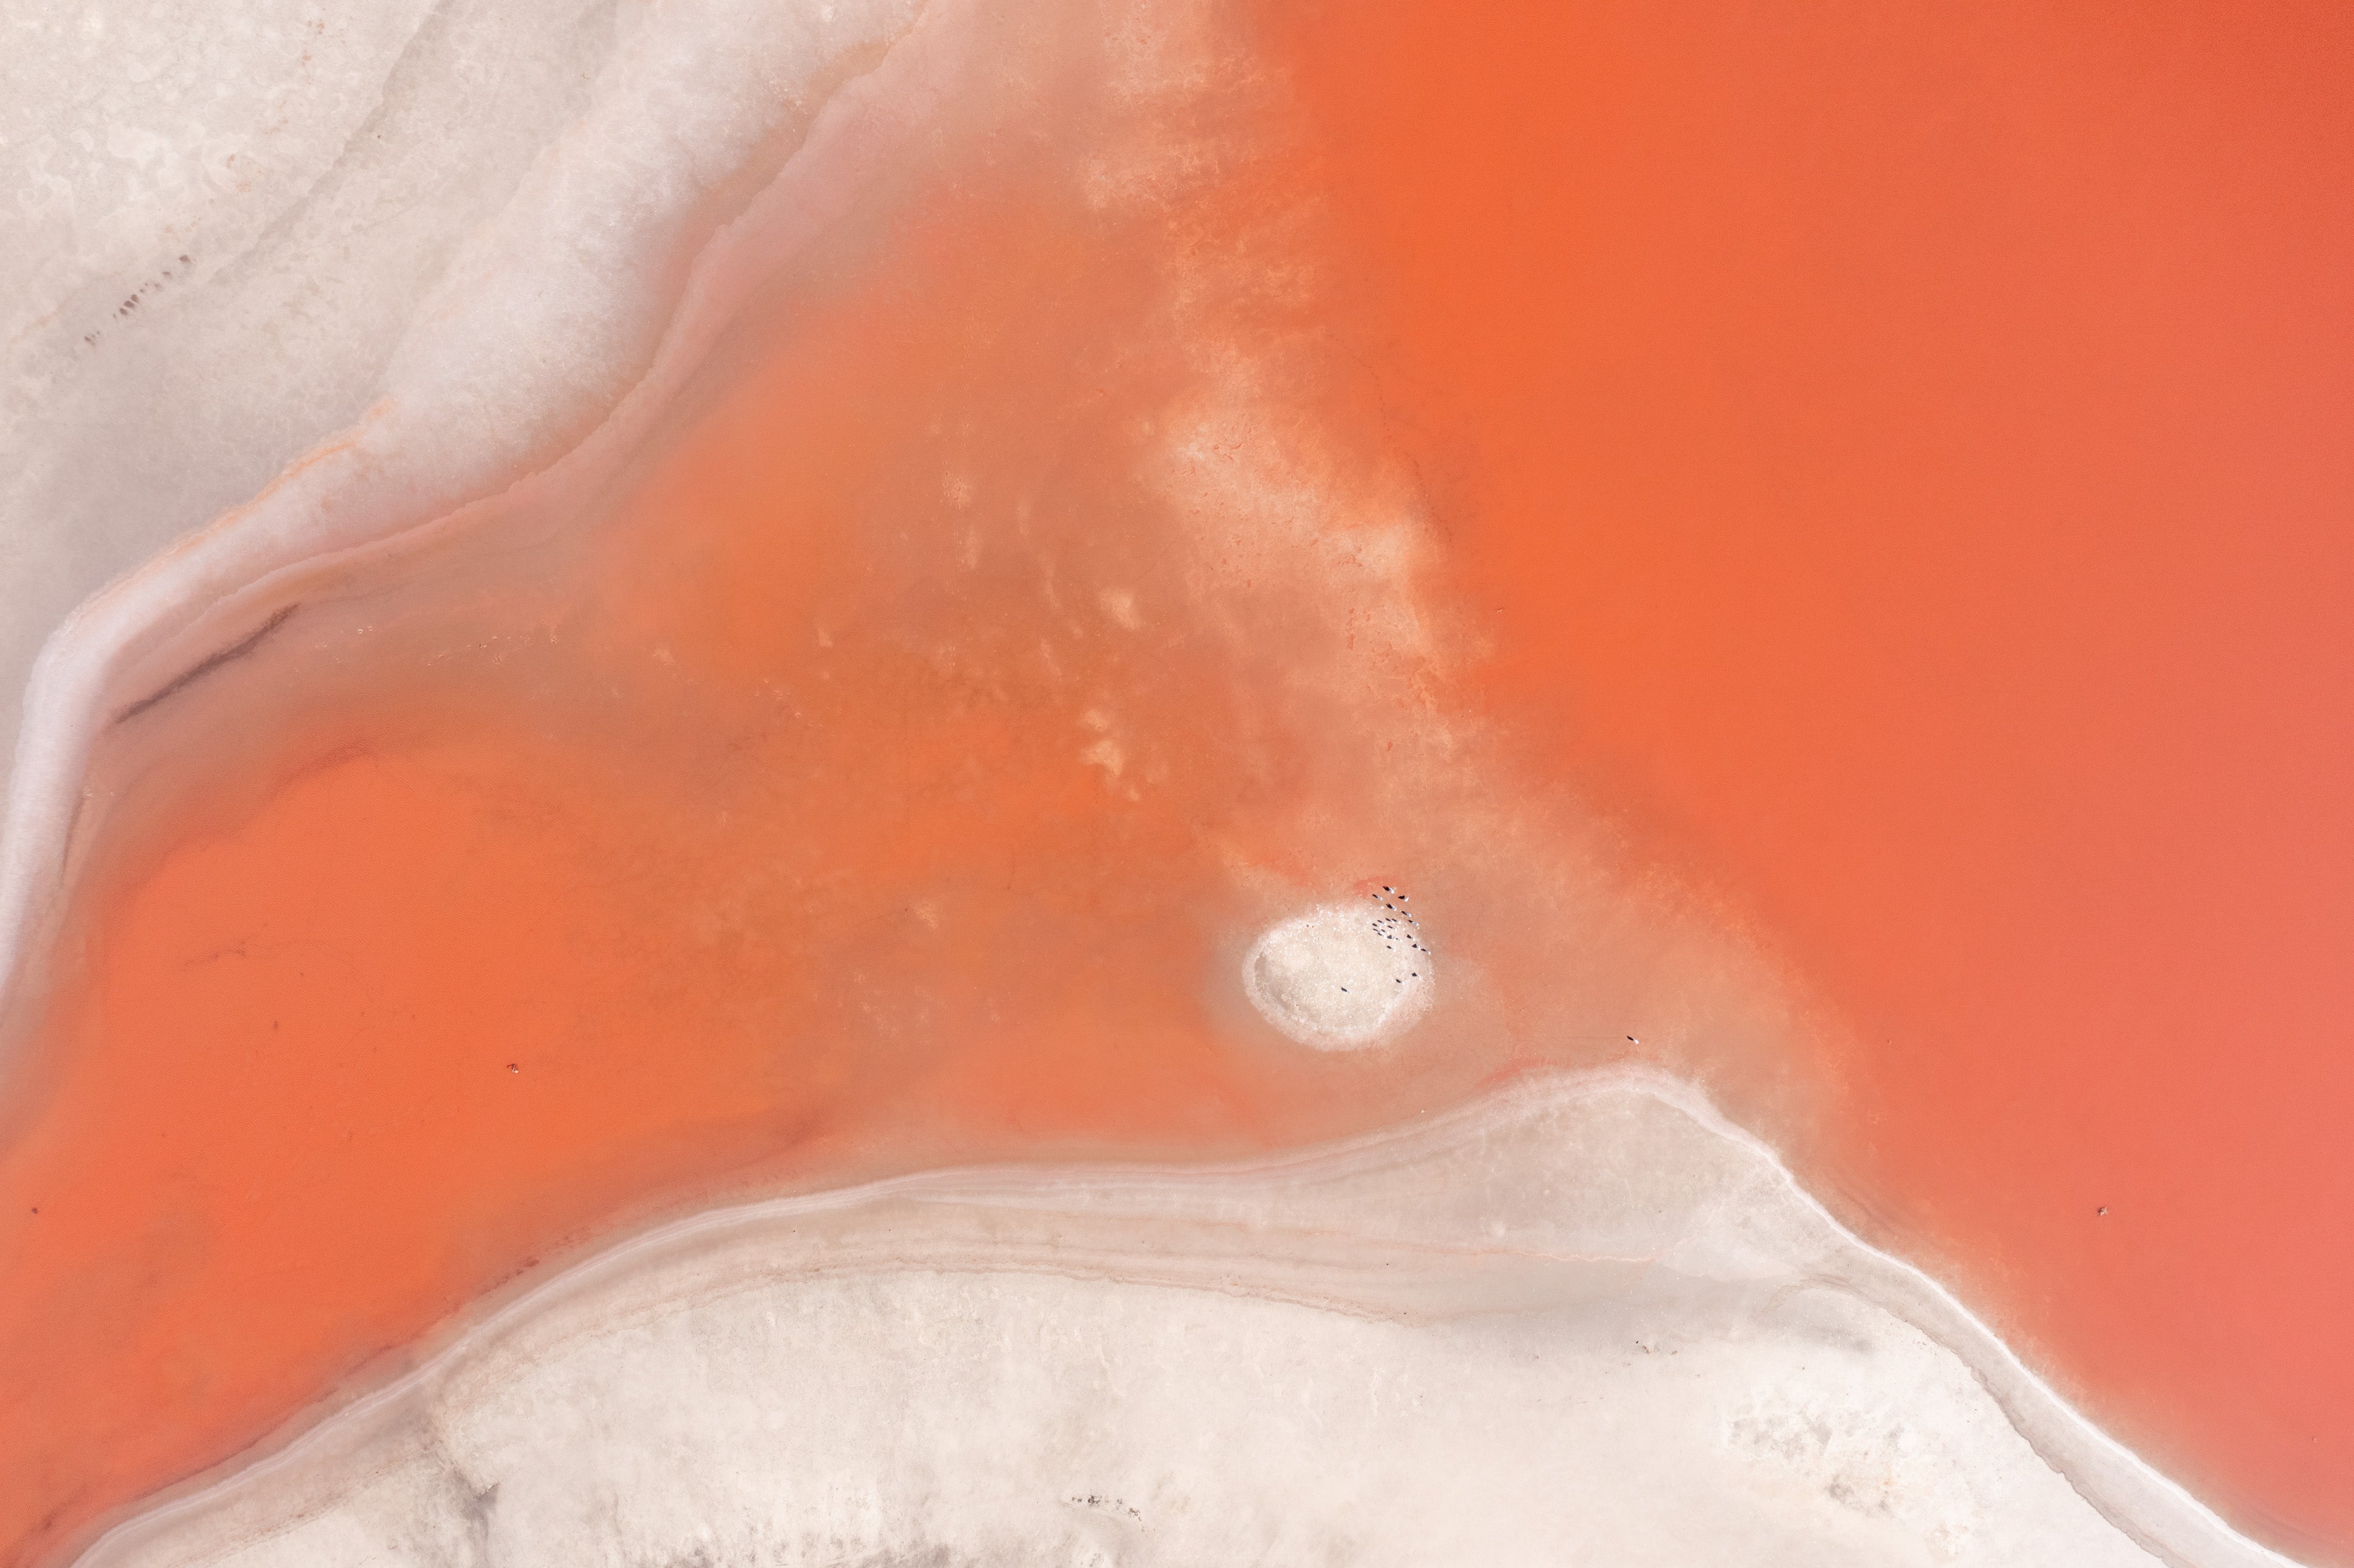

Fine Art For Hotels
Abstract aerial photography of Australian salt lakes - for interior designers, boutique hotels, and business spaces.
-
Open and limited edition prints
-
Multiple prints and sizes available
-
Will meet your budget needs
-
Framed and supplied to your deadline
-
Large range of colourful yet naturally muted tones to suit most interiors
-
Can be made exclusive to your project